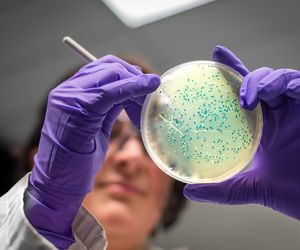
Bakterie żyją w nas: dobre i złe bakterie w organizmie człowieka

Układ odpornościowy
Układ odpornościowy chroni organizm przed czynnikami chorobotwórczymi. Jego zadaniem jest powstrzymanie patogenów przed dostaniem się do ustroju, a także identyfikacja oraz likwidacja rozpoznanego zagrożenia tak, aby nie doszło do powstania choroby lub ustrój szybciej uporał się z agresorem. Uniwersalność układu odpornościowego polega na tym, że radzi on sobie zarówno z wirusami, bakteriami, pasożytami, grzybami oraz różnego rodzaju toksynami. Ma także zdolność do „uczenia się” nowych form patogenów.
Nasz organizm dysponuje dwoma systemami obrony – odpornością swoistą i nieswoistą. Elementami odporności nieswoistej jest m.in. odpowiednie pH żołądka, pot, łój, a także zawarty we łzach lizozym i inne enzymy. Z kolei odporność swoista to komórkowa odpowiedź organizmu na zagrożenie. Jej aktywacja polega na rekrutacji m.in. makrofagów oraz limfocytów T i B.
Samą odporność organizmu można podzielić na czynną i bierną. Ta pierwsza ma związek z wytworzeniem się przeciwciał oraz komórek pamięci w wyniku przebycia infekcji lub podania szczepionki. Część szczepionek jest obowiązkowa, większość ma charakter fakultatywny. Odporność bierna polega na podaniu gotowych przeciwciał z zewnątrz (np. w postaci surowicy w przypadku ukąszenia przez żmiję albo podania noworodkowi pokarmu matki).
Prawidłowe funkcjonowanie układu odpornościowego może być upośledzone przez wiele chorób, które przejściowo lub trwale ograniczają możliwości obronne organizmu. Ich działanie może być niezwykle groźne, ponieważ ułatwia przenikanie do organizmu patogenów, zwiększa ryzyko nawrotu choroby i zmniejsza skuteczność leczenia. Na osłabienie układu odpornościowego wpływa m.in. AIDS, zaburzenia układu hormonalnego, przewlekły stres, stosowanie używek (palenie papierosów, częste picie alkoholu). Również utrzymująca się latami otyłość może prowadzić do upośledzenia odporności organizmu. Leczeniem układu odpornościowego zajmuje się immunologia.